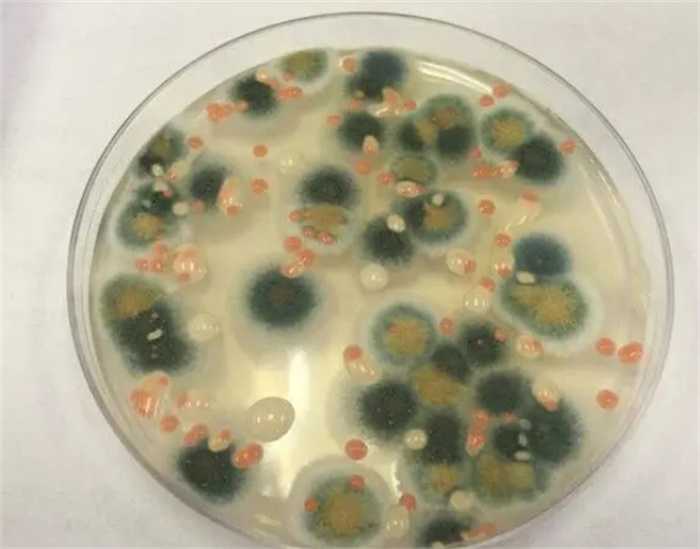

核泄漏造成亿万损失,导致生物变异,还贡献了航空黑科技?
切尔诺贝利核电站的附近发现了一种真菌,这种真菌的奇特之处在于它能够在核辐射的影响下茁壮成长,这种强大的“抵御”能力引起了科学界的关注,天文学、材料学、生物学和物理学都在试图搞清楚该真菌的存在原理,并试图应用其在人类活动中。
切尔诺贝利核电站
切尔诺贝利一共有四个核反应堆,1982年9月,1号反应堆中的堆芯因为冷却阀故障而融化,反应堆中的铀在这之后因过热而破裂。不过这并不是一个不可挽回的大事件,损坏的程度相对较小,没有人在事故中丧生。
然而,由于操作员的疏忽,几个小时后该事故才被上报,上报的时候大量辐射已经从反应堆中逸出。这整个事件可以被认为是为真正的切尔诺贝利事件埋下了种子,1号反应堆的操作疏忽和上报延迟,都为后续真正的核电站爆炸事件留下了伏笔。
四年后,4号反应堆因为灾难性的功率增加导致堆芯爆炸,接着引发了难以扑灭的露天火灾。两者结合,大量放射性物质和同位素扩散到大气和核电站周围的土地中。这被认为是核电历史上最严重的事故,没有之一。
这之后,切尔诺贝利核电厂的4号反应堆被完全摧毁,后被封闭在一个混凝土和铅制的石棺中,再被一个大型钢制封闭掩体所包围,为的就是防止放射性物质进一步逸出。但是在这些复杂的掩体建成之前,已经有很多地区受到事故的影响。
核辐射的后果
切尔诺贝利核电站的事故发生后到底对当地乃至整个欧洲的环境造成了怎样的影响,如何影响了生态系统和人类身体健康,这些问题一直都没有定论,只能不断地研究下去。一方面,人类在此之前没有经历过类似的事件,根本没有前情可以参考。
另一方面,研究核辐射本身就是一个难度很高的任务,研究成本不仅局限于金钱,也包括研究人员的身体健康。表象上来看,在切尔诺贝利附近,放射性尘埃云杀死了大面积的松树,死树生锈并且变成了红橙色。

不过同一地区的其他物种,如白桦树,却在这之后幸存了下来,表明植物物种对辐射的敏感性可能有很大差异。该地区动物的突变畸形病例包括白化病和外部畸形,另外还有昆虫突变。
空气中的放射性污染对该地区的动物群、植被、河流、湖泊和地下水都立刻产生了明显的负面影响。另外,各种奇怪的物种也出现了,并不单指那些变异的畸形动物,也包括所谓的可以抵抗辐射的真菌。
抗辐射真菌对人类很重要?
切尔诺贝利附近发现的真菌被统称为放射性真菌,或放射性营养真菌,科学家观察到它们的菌丝生长指向放射性石墨,这种现象在生物学上称为“向辐射性”。另外在一些反应堆的冷却水中也发现了丰富的真菌,真菌细胞膜中的吸光化合物具有使水变黑的作用。
更重要的是,科学家们一开始假设这种放射性真菌是一种进化过的真菌,也就是说它在极端条件下生活久了之后给自己进化出了针对核辐射的屏障,但事实证明并不是这样,放射性真菌会因为辐射而生长得更好,它们甚至从辐射中提取营养。

进一步的研究表明,放射性真菌在辐射水平比正常环境水平高500倍的环境中生存时,它的生物量和醋酸盐积累速度更加快。这些真菌中都含有黑色素,首先,黑色素本身就具有防辐射特性,因为它具有高分子量,可以转换和屏蔽能量,吸收包括光在内的电磁辐射。
其次,黑色素是真菌的一个优势,因为它有助于它在许多不同的、更极端的和多变的环境中生存。这些环境的例子包括受损的切尔诺贝利反应堆、国际空间站和南极山脉。黑色素也可以帮助真菌代谢辐射转化为能量,但仍需要更多的证据和研究。
最后,黑色素的生成可能会以真菌细胞的一些代谢成本为代价,在没有辐射的情况下,一些无黑色素真菌比有黑色素真菌生长得更快。由于真菌细胞壁中的黑色素分子会形成有毒中间体的原因,营养物质可能被限制了吸收。
地球的大气层和磁场保护人类免受有害辐射,然而宇航员所接受的辐射水平是地球上辐射水平的20倍。而放射性真菌具有将伽马辐射转化为化学能的功能,因此它可能未来会在航空领域大展拳脚,展现它阻挡辐射的能力。
大家都在看
-
为何天上有颗“深圳星”?深圳科技馆馆长跟你聊宇宙探索、讲科学故事 开栏语星河浩瀚,藏着无尽奥秘。今起,本报推出“馆长唠科”专栏,由深圳科学技术馆馆长郑永春先生执笔,以天地为视野,聊宇宙探索,讲科学故事。首期,我们一同走近“深圳星”,看看这颗镌刻着鹏城名字的星星藏着哪 ... 宇宙探索03-24
-
从量子科技到元宇宙的崭新探索:中国科技为何引起全球瞩目? 合肥的实验室中,当光量子芯片在-271℃的超低温环境下闪烁着神秘的幽蓝光芒,显示着我国在前沿科技领域的前沿探索;在深圳,柔性屏幕薄如蝉翼,如同丝绸般可卷曲,展现了我国在新材料领域的创新实力;而在上海的生物 ... 宇宙探索03-23
-
显微镜下的奇妙世界:探索微观宇宙的无限奥秘 在我们的日常生活中,眼睛所能看到的世界仅仅是浩瀚宇宙的冰山一角。无数精妙的细节与宏大的结构,往往隐藏在肉眼无法触及的微观尺度之下,静默地运转着。而显微镜的发明,宛如一把神奇的钥匙,为我们打开了一扇通往 ... 宇宙探索03-23
-
《宇宙探索编辑部》追了半生宇宙,才懂平凡人间,才是终极答案 作为看遍各类科幻与现实题材的影评人,很少有一部电影能像《宇宙探索编辑部》这样,没有炫酷特效,没有惊天反转,却用最笨拙、最赤诚的理想主义,戳中无数人心里最软的地方。我们都曾像主角唐志军一样,抱着一份不被 ... 宇宙探索03-22
-
一个国家插入另一个国家? 一个国家插入另一个国家腹地会有什么影响?就像位于西非的冈比亚和塞内加尔。冈比亚占据冈比亚河下游两岸的狭长地带,犹如一把匕首插入塞内加尔中。冈比亚河是西非唯一通航海船的河流,由于冈比亚控制了主航道,内陆 ... 宇宙探索03-22
-
探索微观宇宙,见证科技奇迹!🔍🔬✨ 在这个由精密齿轮构成的微观宇宙里,每个细节都决定着系统的命运。一个微小的错位就能让整个系统陷入停滞,这就是系统的脆弱性,对细节的敏感度超乎想象。而点滴的校准是引导能量流向的关键。当细节被精准把控,能量 ... 宇宙探索03-22
-
第十九章:万灵共振,探索宇宙的奥秘,见证生命的奇迹!🚀✨ 唤醒生机之种的过程成了全银河生灵的共同使命。联盟向所有星球发出号召,用最纯粹的希望与勇气向枯寂星传递意念这两种情感。在法则层面恰是光的存续与暗的革新最鲜活的体现。·一、时间新银河的每一颗星球上,无论是 ... 宇宙探索03-21
-
探索宇宙的奥秘,揭开宇宙的神秘面纱!🔍🔬 宇宙究竟是平坦的还是弯曲的?这个问题让无数科学家和天文迷争论不休,真相究竟是什么?宇宙是否平坦一直是天文学界的一个热门话题。根据广义相对论,如果宇宙是平坦的,那么光线在宇宙中就能直线传播,不会发生弯曲 ... 宇宙探索03-19
-
太空探索:人类如何一步步走出地球,开启宇宙之旅 说起太空探索,很多人脑海里浮现的可能是宇航员穿着厚厚的宇航服,驾驶飞船飞向月球或者火星的画面。但其实,太空探索的故事远比这些画面更精彩、更复杂,也更充满了人类的智慧和勇气。今天咱们就来聊聊,这场人类走 ... 宇宙探索03-18
-
探索宇宙的奥秘,从大爆炸到黑洞,带你走进神秘的星空世界! 先说大爆炸吧。想象一下,138亿年前,整个宇宙其实是一个极其炽热、密度超高的“火球”,比太阳还要热千万倍,空间几乎没有。突然,这个“火球”开始疯狂膨胀,速度快得难以想象,这就是大爆炸。别误会,这不是普通 ... 宇宙探索03-18
相关文章
- 商业航天如何推动人类探索宇宙
- 太空探索:人类如何一步步走出地球,开启宇宙之旅
- 探索宇宙的奥秘,从大爆炸到黑洞,带你走进神秘的星空世界!
- 探索宇宙奥秘:地球的起源与生成之旅🌍✨
- 探索未知宇宙苍穹
- 北京天文馆“宇宙探索营”开启\中国人民抗日战争纪念馆卢沟桥抗战半景画全新升级……本周最新博物馆资讯点击——
- 从《宇宙探索编辑部》到《坠落的审判》,他用60余张海报设计解码光影背后的“无序公式”
- 科学家追踪引力波,结果发现更离谱的宇宙事件
- 以光速的20%飞行:科学家展示“实用”光帆探索宇宙
- 看不见的宇宙:暗物质与暗能量的证据、理论与探索
- 美国太空部队:要有攻击中国卫星能力,探索部署攻击性轨道航天器
- “大航天时代”会加速人类探索宇宙的进程吗
- 三种“超光速”现象,告诉你宇宙远比想象疯狂
- 微积分:探索宇宙无限奥秘的钥匙
- 探索月相奥秘,揭示宇宙的奇妙!🌙✨
- 宇宙或许不是无限的,它的总质量已经被推算出来
- 探索宇宙的奇迹,太空站俯瞰地球!🌍✨
- 宇宙探索:人类的火星梦想与深空探测
- 从水火土到夸克 2500年物质探索 重塑宇宙认知
- 暗物质捕手+天文AI,中国科学家把宇宙探索“卷”出新高度
热门阅读
-
预言2030年太阳将休眠,恐怖的千年极寒将来临 07-11
-
中国十大元帅之死,多高寿而善终(林彪叛逃而死) 07-11
-
因果报应真实事例,做尽坏事必遭天谴 07-11
-
这6个神奇天体有很酷的名字 06-01
-
全球人口减少可能带来的六大教训和好处 07-18
-
离太阳最近的十大恒星排名,宇宙最大十大星球 04-12
精选文章
- 创生之柱是什么?(创生之柱给予了许多恒星生命)
- 中国51区秘密基地,窃密必被抓(抓住就杀头)
- 中国“天宫”空间站将在2022年前后建成 呈T字型有三个舱段最多可驻留6人 ...
- 新冠病患康复后,可能“精子减少或无精”
- 中国古代四大凶兽,四大神兽vs四大凶兽谁更强
- 2025年宇宙探索大爆发!月全食、火星冲日等,这些天文奇观别错过
- 黑龙江50万年死火山苏醒, 内含15%电量的巨大岩浆囊
- 误会一辈子!破伤风其实是一种细菌跟生锈铁完全没关系
- 美国同步空间态势感知项目(GSSAP)军事间谍卫星多次秘密靠近俄罗斯和中国的航天器 ...
- 中国长征五号B遥一运载火箭全貌曝光 本月底在海南文昌航天发射场进行首次发射 ...
